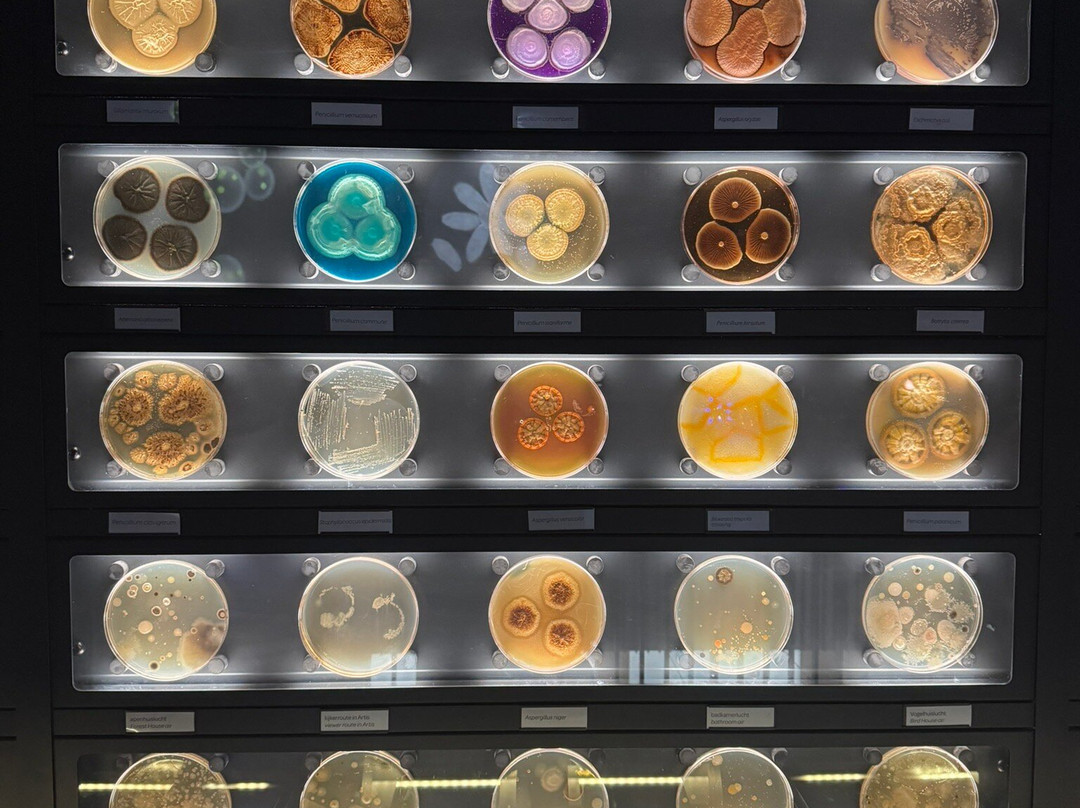

TripAdvisor LLC 既不是预订代理商,也不是旅游运营商,不会向网站用户收取任何服务费。 按照规定,在 Tripadvisor 发布机票价格、游览和旅行套餐的合作伙伴(航空公司、旅行提供商及预订代理商),其标价须包含所有费用和附加费用。 例如, 机场出入境税费、消费税与其他服务费、手续费、杂费及附加费用。 当您向我们的某个合作伙伴进行预订时,请务必查阅他们的网站以了解当地行政部门要求的所有适用费用的具体情况。 除非另有说明,机票价格通常指的是一个人的价格(以人民币计)。
为方便起见,TripAdvisor LLC 根据从我们的预订合作伙伴获取的空房率计算每个酒店的均价。 对于游览和景点来说,所显示价格通常是每位成人的最低可用价格。 对于列出的任何旅行套餐或优惠,TripAdvisor LLC 无法保证任何特定的费率或价格。 此外,酒店均价每晚会更新,并以您的首选币种表示(使用现行汇率)。 由于这些已换算的价格是预估价格,因此,有关具体金额和币种请与预订网站进行核实。
此外,TripAdvisor LLC 无法保证我们网站上宣传的价格随时有效。 标价可能需要预订一定天数才能生效,或有不可用日期、使用条件或限制。
沪公网安备31010502005427号